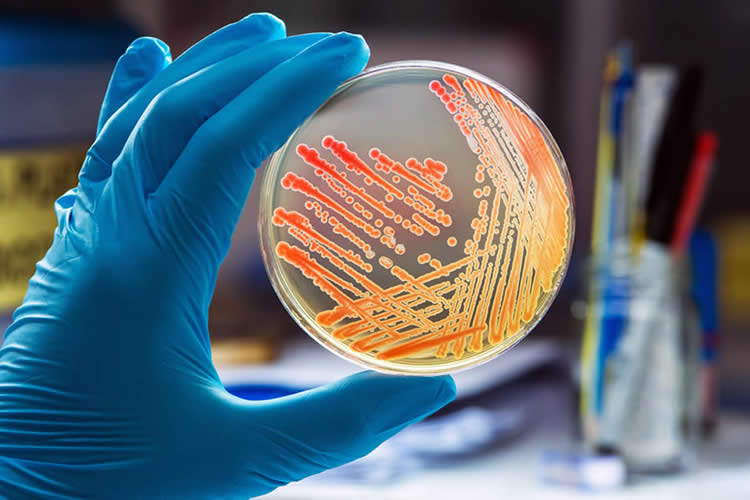
Analisi acqua Biella, microbiologiche, chimiche, campionamento, consulenze e manuali HCCP

Il Laboratorio CDV LOREN 2 esegue Analisi acqua Biella microbiologiche su:
- Analisi acqua Biella di rete/di pozzo/sanitarie: controllo potabilità, ricerca Legionella spp e pneumophila
- Alimenti
- Supporti da campionamento superfici ambienti del settore alimentare
I batteri giocano un ruolo importante nella produzione e conservazione degli alimenti; alcune specie possono essere utili nella produzione di alimenti (ad esempio le colture per la produzione di formaggi), altre indicano una scarsa qualità igienica (indicatori d’igiene) o costituiscono addirittura un potenziale rischio per la salute umana (microrganismi patogeni).
I parametri più frequentemente ricercati sono:
- carica batterica totale (carica mesofila)
- indici di scarsa qualità igienica e di deterioramento: Coliformi, Escherichia coli, Enterobatteri, Lieviti e Muffe, ecc.
- patogeni che causano infezioni alimentari: Salmonella spp, Listeria monocytogenes, Bacillus cereus, Stafilococchi, Clostridi, ecc.
L'analisi microbiologica si basa essenzialmente sulla semina di un’aliquota di campione, opportunamente preparato a varie diluizioni, su “terreni colturali”, distribuiti in piastre, seguita dall’incubazione in idonee condizioni. Durante il periodo d’incubazione i microrganismi si moltiplicano fino a formare delle colonie visibili a occhio nudo. L’analisi prosegue poi con l’identificazione delle specie o dei gruppi microbici presenti nel campione, in modo da permettere la formulazione di un giudizio igienico-sanitario.

Il Laboratorio CDV LOREN 2 è in grado di fornire Analisi acqua Biella chimiche su:
-
Alimenti: Analisi acqua Biella multiresiduale, micotossine, metalli, allergeni, etichette nutrizionali
-
Analisi acqua Biella su Analisi acqua Biella destinate al consumo umano, su Analisi acqua Biella di piscina e su acque reflue
-
Analisi acqua Biella di terreni
Le Analisi acqua Biella chimiche sono fondamentali per rilevare i contaminanti chimici che possono mettere a rischio la salute umana, la salubrità di un alimento, o un ecosistema ambientale.
Tali contaminanti sono molti e di diversa natura, come molteplici possono essere le fonti della contaminazione.
Per fare questo ci avvalliamo della collaborazione di laboratori esterni di comprovata esperienza, accreditati da ACCREDIA.
Campionamenti presso realtà produttive, commerciali e servizi alla persona
Fin dall’inizio della sua attività, CDV LOREN 2 si è specializzata per effettuare campionamenti su:
- Alimenti
- Superfici di ambienti di lavoro nell'ambito dell'industria alimentare
- Analisi acqua Biella destinate al consumo umano (acque di rete e di pozzo)
- Analisi acqua Biella sanitarie
- Analisi acqua Biella di piscina
- Aria
I prelievi, su programmazione, possono essere eseguiti dal nostro personale direttamente in un area geografica compresa in Piemonte, Valle d'Aosta e Liguria.

L’elenco completo delle nostre prove accreditate è disponibile sul sito web di ACCREDIA
